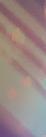

Q: WHY DO YOU REFER YOUR GUESTS TO THE WELCOME GUIDE, AND WHAT MAKES IT AN ESSENTIAL RESOURCE?
A: New York can be overwhelming with all the options of where to go and what to do, The Welcome Guide has a breakdown of the neighborhoods and suggestions in each neighborhood (restaurants, shows, museums, attractions etc.). It’s an important resource for us Concierges because we don’t have to google each museum and Broadway show to find information. The Welcome Guide has which shows are opening and closing, addresses of theaters, and a synopsis of each show; it also has a synopsis for the museums, The Welcome Guide is the Bible for Concierges.
Q: WHAT’S AN EXCELLENT SPOT TO CAPTURE A GREAT SELFIE?
A: On the Staten Island Ferry. You have spectacular views of the Manhattan skyline and the Statue of Liberty. After departing Manhattan stay at the back
of the boat to get that selfie of yourself with the water in between you and the Manhattan skyline. Then go to the side of the boat to get a selfie with Lady Liberty.
Q: WHERE’S THE BEST PLACE TO TAKE KIDS OF ALL AGES?
A: The Museum of Illusions. The Museum is dedicated to playing tricks on you. Clear your storage in your cameras to take a hundred pictures or more. Also, the St. Patrick’s Day Parade, Tartan Day parade and Easter parade are so much fun!
Q: WHAT IS YOUR EXPERT TIP?
A: Ask your concierge what’s happening weeks before you arrive. Concierges are on top of what’s happening in NYC. Concerts, sporting events, Parades, street fairs, marathons, UN in session etc., can change your course drastically if you’re not aware. And, of course, before you arrive in NYC, check out wheretraveler.com to be in the know about what’s happening in NYC!

EXECUTIVE
CEO/PUBLISHER
Peter Flower p.flower@govisit.media
GENERAL MANAGER OF DIGITAL MEDIA
Paul Bausch
EDITORIAL & DESIGN
EDITOR-IN-CHIEF
Melanie Lee melanie.lee@govisit.media
GRAPHIC DESIGN
Hideki Kato, Hiroko Egashira CONTRIBUTORS
Meryl Pearlstein
PHOTOGRAPHER
Alan Battman, William Delisi
WEBMASTER
Sana Mola IT MANAGER
Todd Gorgon CIRCULATION
Sal Fiore circulation@govisit.media
ADVERTISING
VP OF SALES & MARKETING
Duke Brodsky duke@govisit.media
BUSINESS DEVELOPMENT MANAGER
Alexandra Dominguez a.dominguez@govisit.media
ADMINISTRATION
BOOKKEEPER
Alex Avin alex.avin@govisit.media
For advertising inquiries



You can feel it in the air—New York City is back. There’s an energy that signals what we all know and love – this is the one-and-only New York City. The city that never sleeps is gradually crawling out of an enforced nap with a buzz and activity that says, “Hey, check us out.” Whether it’s your first visit or your 50th, here are some tips and tricks to help you navigate the concrete jungle in its current state.

Are you feeling under the weather? If you’re in need of a COVID-19 test, you’ll quickly find testing kiosks on many prominent street corners. You can also find testing facilities inside pharmacies like CVS, Rite Aid and Walgreens. Rapid testing options are available as well, in case you need to know your test results quickly
for travel back home. Flu tests are also available at some testing facilities, and it’s also easy to find flu and COVID-19 vaccines around the city.
If you’re hoping to see as much as possible on your trip, make sure to purchase tickets and make your reservations as soon as possible. Many venues still utilize timed tickets to encourage social distancing and allow for more space (this also means better photos for you). Some attractions are also seeing significantly increased attendance which can mean sold-out times/dates. Book ahead to ensure you see everything you want to see on your trip to the Big Apple!
Take time to relax. New York can be an exciting but also hectic place. Just because the city never sleeps doesn’t mean you don’t need to! Make a stop back at your hotel to recharge and drop off shopping bags or visit one of the many stunning parks and green spaces in the city for a mid-day pick-me-up. You can also find a little peace and quiet while admiring the art in some of the city’s stunning museums.
Enjoy the nightlife. New York is one of the most vibrant cities in the world after dark, with plenty of bars, clubs and lounges to explore. Don’t forget to visit Times Square at night—even if you have already visited during the day. When the city lights are on after dark, everything looks extra vibrant.

Make sure you’re aware of the subway schedules, so you don’t get stuck late at night. Many lines don’t run overnight, so you’ll want to make sure you know the schedules for substitute lines that are going to those areas (or close).
Eat out, tip well, go to museums, gardens and parks. There’s so much to do as New York City continues to move forward—everything from Broadway shows to brand-new restaurants and attractions. For updated health and safety information when visiting as well as daily updates, visit coronavirus.health.ny.gov.





From brews (hops at Bronx Brewery) to brews (beans at Blue Bottle Coffee), the options are endless at Hudson Yards. Stock up on French confections from Ladurée, grab the cupcakes Carrie Bradshaw made famous at Magnolia Bakery, pick up tapas from Mercado Little Spain (the brainchild of Chef José Andrés and the Adría Brothers), or dine on upscale Greek cuisine and the freshest catches at Estiatorio Milos.
Hudson Yards is so much for than just shopping and dining. Catch a show or exhibit at The Shed, a multi-use art and performance venue that features everything from live dance to art shows. Venture to The Edge for the tallest outdoor sky deck on this side of the globe. If you’re feeling especially adventurous, book a session with City Climb and scale the side of the building 1,200 feet high. You can’t beat those views!
Hudson Yards is a shopper’s paradise with everything from luxury goods to designer finds and more. Grab that once-in-a-lifetime piece from Cartier, this season’s latest handbag at Coach, fashion finds at H&M, tongue-in-cheek greetings at Lovepop, athleisure apparel at Lululemon, and so much more. Whether you’re looking to drop some serious cash on a shopping spree or find an inexpensive last-minute gift, you’ll find it here.

By Melanie Lee
The Book of Mormon on Broadway is one of the most popular musicals currently running in New York City. Written by South Park creators Trey Parker and Matt Stone, the musical follows two mismatched missionaries as they journey to a remote Ugandan village hoping to convert locals to Mormonism. With its clever tunes, laugh-out-loud humor and surprisingly touching moments, The Book of Mormon has earned its place among Broadway classics. From the catchy opening number “Hello!” to the show-stopping eleven o’clock number, “I Believe,” this hilarious show will surely leave audiences singing and dancing in their seats. Featuring some of the best writing and performances on the Great White Way, The Book of Mormon’s biting satire and outrageous comedy will keep you engaged from start to finish. We talked with Kevin Clay, who plays Elder Price in The Book of Mormon, about the show’s continuous success since its opening.
W- The Book of Mormon has been a hot ticket ever since its opening over a decade ago. To what do you attribute the show’s success?
Clay- The core of this show’s success and lasting power is its uniqueness to the Broadway world. The writers, Trey Parker, Matt Stone and Bobby Lopez, pay plenty of tribute to the musical theatre canon, but they have created something unlike anything seen before and anything still to come to New York.
W- Many shows that feature a significant level of satire come across as cheesy or overdone, but not The Book of Mormon. How does the production tow the line so well?
Clay- I think the oftentimes ruthless satire and raunch keep audiences off balance in a way that fuels their desire to see just where this crazy show is going to take them. At the core of everything, though, beyond the witty writing and brilliant music, this show has a pure heart. The message of this show is ultimately one of absolute positivity, to find a life and a world that al-

lows a person to be their truest self while serving your community with specificity and goodness.
W- The show has been featured internationally and has seen success in numerous other countries. What do you think makes The Book of Mormon appeal to the masses internationally?
Clay- I had the privilege to perform with this show throughout Europe, so I could see with my own eyes the impact it has internationally. Firstly, so many European countries love musical theatre but don’t get a ton of it. Our show, especially musically, fits the bill of classic musical theatre at its finest, which is received so well. Secondly, they have the added bonus of watching Elder Price and Elder Cunningham as the displaced yet overly confident Americans that they are. I chatted with many viewers during my time overseas, and they were never shy about how funny it was to laugh at “us Americans.” Then that heart of gold I spoke of earlier shines through, and the universal message to do good and not do what is expected resonates and creates fans wherever the show goes.




BY MERYL PEARLSTEIN
Did you know that Tokyo is New York City’s first Sister City? Perhaps that’s why we are fascinated by the cherry trees that show up in parks all over the city in the spring. Many trees were gifts from Japan, further fostering a pink friendship between the two cities.
As spring trees bloom, the ones that elicit the most oohs and aahs are the cherries, the sakura. There are whites, pale pinks and vivid fuchsias. They stand tall, they spread wide, or they droop like weeping willows. For just a few months through the end of May, the varieties of cherry blossom trees bloom on varying schedules, with timing significantly dependent on the weather.
Notable gifts from Japan to the US in 1912 and later from the Committee of Japanese Residents of New York have created Riverside Park’s (212.870.3070, nycgovparks.org/parks/riverside-park) gorgeous Cherry Walk. The stretch of the park from 100th to 125th streets is named for the Prunus cherry trees that line it and is again filled with cyclists and strollers. Reflections off the Hudson River make this an exceptionally beautiful area to spend time and contemplate how lucky you are to be in New York City during this glorious season.
Central Park (212.310.6600, centralparknyc.org) has an area called Cherry Hill on 72nd Street, with stunning views of the pink and white trees. Central Park’s Yoshino cherries are also a gift from the government of Japan and can be found in abundance on the east side of the Reservoir and behind the Metropolitan Museum of Art (1000 Fifth Ave., 212.535.7710) as you head towards the Great Lawn.
The queen of private gardens when it comes to hana-

mi, the Japanese tradition of celebrating the transient beauty of flowers, the Brooklyn Botanic Garden (990 Washington Ave., 718.623.7200, bbg.org) takes the guesswork out of when the cherries are blooming with their Cherry Watch online schedule—it is updated frequently so you can see which trees are blooming in which areas, especially helpful if you prefer pink Kanzan ones to whitish Yoshinos or an allee of trees where you can sit, paint or just meditate.
The two main draws are the aforementioned Cherry Esplanade and the Japanese-Hill-and-Pond Garden. It’s easy to envision yourself swept away to Japan when you look at the lovely trees and a beautiful vermillion torii set against the pond. Adding to the Japanese-inspired setting, the waters are filled with koi, as you might see in the Imperial Palace Gardens in Tokyo.
More than 200 cherry trees are scattered throughout the expansive New York Botanical Garden (2900 Southern Blvd., Bronx, 718.817.8700, nybg.org), beginning with the entry walkway. The mix of Japanese art and Japanese cherries creates a transportive effect as you roam the grounds. The New York Botanical Garden’s Cherries Tracker will help guide your visit so you’ll know where and when to focus your time.
Take a stroll through many neighborhoods of New York City, and you’re bound to run into the beautiful blossoms along the way. Parks like Union Square Park (201 Park Ave., S., 212.460.1200, unionsquarenyc.org) and Prospect Park (718.965.8951, prospectpark.org) are easy to wander by, and you’ll find the blooms on display. Neighborhoods like Brooklyn Heights and Red Hook are also prime places to stroll for a great view of the cherry blossoms. You also can’t go wrong with a walk on the High Line.


New York City is an iconic destination that offers something for everyone. For those looking to get away from it all, a weekend in the city can be just what they need to recharge and explore all the incredible metropolis offers. Here are a few suggestions for a fun-filled weekend in New York City.
The family of Boucherie restaurants in New York City is always delightful, but a visit to La Grande Boucherie (145 W. 53rd St., 212.510.7714, boucherie. NYC) is a total vibe. The restaurant recently introduced breakfast—so you don’t have to save the brunch dates for weekends. You’ll find everything from lighter fare (fruit salad and granola) to more brunch-esque choices like the Pain Perdu. Sandwiches and egg options are also plentiful and hearty. You can’t beat the ambiance in the stunning atrium-style space filled with greenery and charm. Times Square is a quick stroll from the restaurant and offers all of the lights and wonder you’ve surely seen in photos and films. Stop by the TKTS booth for discounted show tickets for your visit, take your photo on the red stairs and do a little souvenir shopping.
You’ve probably got just enough time for one last stop before heading back to reality. Even though the hit sitcom was mostly filmed on studio sets in Los Angeles, it doesn’t mean you can’t truly enjoy The FRIENDS Experience (130 E. 23rd St., friendstheexperience.com/new-york) in New York City. A visit takes you behind the scenes of the show, where you can walk through various displays of costumes and pieces from the show amongst set recreations and the hilarious photo opportunities. Step into Monica’s apartment, ride “Pat the Dog,” and grab a real cup of coffee at Central Perk.


Explore the Museums in NYC
The American Museum of Natural History (200 Central Park West, 212.769.5100, 212.769.5100, amnh.org) is a truly spectacular sight to behold. Founded in 1869, the museum is home to some of the world’s most remarkable and diverse collections of natural history artifacts, ranging from ancient fossils and dinosaur bones to vibrant living organisms and ecosystems. Spanning four city blocks, the museum houses over 32 million specimens and contains a research library with over 700,000 volumes.
In the mood for seafood? Sample the freshest catches and a wide range of raw and cooked options at Mermaid Oyster Bar (89 MacDougal St., 212.260.0100, themermaidnyc.com). The newest location in Times Square (127 W. 43rd St., 332.208.7713) provides a cozy vibe despite its cavernous space, and it’s the perfect place to enjoy oysters and anything from the sea. Try specialties like the Lobster Knuckles, served escargot-style (but without the snails). If you’re feeling extravagant, indulge in a seafood
platter (they come in multiple sizes to fit different appetites and group sizes).
What’s a trip to New York City without some worldclass entertainment for which the city is known? No matter what you enjoy, there’s a show that’ll blow you away. From world-renowned musicals like The Book of Mormon to dramatic (or comedic) stage productions and theatrical renditions of blockbuster films, there’s truly something for everyone in the theater district. If you’re unsure where to start, flip to our Entertainment Guide on page 23!
After your show, you’ll want to venture over to Times Square to see the dazzling screens in all their brightly-lit glory for some obligatory NYC photos. Stop in at Junior’s Restaurant & Bakery (1515 Broadway, 212.302.2000, juniorscheesecake.com) for a late-night bite. The restaurant stays open until 11 p.m. on early nights. Make sure to try a slice of Junior’s famous cheesecake. It’s the perfect way to cap off your first night in the Big Apple!
Sleep in and then start your day by Central Park. Sarabeth’s (40 Central Park S., 212.826.5959; sarabethsrestaurants.com) is a beautiful option for brunch and lunch selections like the “Classic Lobster Roll” and the “Miso Glazed Faroe Island Salmon.” Make sure to save room for a light dessert like “Sarabeth’s Cookie Plate” or something more decadent like the “Chocolate Truffle Cake. After brunch, take a leisurely stroll through Central Park. Make time to wander and explore the park and its surrounding streets— there’s a lot to see!



The Museum of Broadway (145 W. 45th St., themuseumofbroadway.com) is a unique destination for anyone interested in learning more about the history and growth of musical theater. Located in the heart of Manhattan’s Times Square, the museum provides visitors with a deeper appreciation of all aspects of Broadway, including its performers, directors, designers, playwrights, composers and lyricists. Visitors can delve into costumes, original television broadcasts and footage from past performances.
Make The McKittrick Hotel (530 W. 27th St., 212.904.1883, mckittrickhotel.com) the big stop for your evening for a truly memorable evening. On any given night, there’s fantastic entertainment and delightful dining unlike anywhere else. Book tickets for At the Illusionist’s Table and enjoy the most intriguing dinner party with charming illusionist Scott Silven (book quickly as experiences tend to sell out). Experience an immersive retelling of Shakespeare’s Macbeth at Sleep No More. The Strange Undoing of Prudencia Hart and Speakeasy Magick also provide exciting entertainment options for your night at The McKittrick Hotel, while a visit to Gallow Green takes diners to a delightful rooftop space with chic craft cocktails and delicious seasonal fare. Events vary by day and month, but no matter what experience you choose, you’re sure to have an unforgettable evening.






Nobody knows New York City like a local. Some of the city’s notable locals are also the stars of Broadway’s multitude of fantastic shows. We talked with NaTasha Yvette Williams, who plays Mary Sue in one of Broadway’s newest shows Some Like It Hot.


W- How did you get your start in performing and in what other shows have you performed?

Williams- I have been performing since age three. I started in Church and then school and then regional theater and then college and New York City. My Broadway Debut was Sofia in The Original Color Purple. I was Mariah in THE Gershwin’s Porgy and Bess. I was also in A Night With Janis Joplin, TINA! The Tina Turner Musical, Chicken and Biscuits, I played Becky in Waitress and Mama Morton in CHICAGO.



W- What are your favorite NYC local tips?

family and friends when they visit?
Williams- I love to go to the Sugar Bar on Thursday Nights for Open Mic. I love Melba’s for dinner, as well as Glass House Tavern and Brooklyn Chop House.

Williams- My New York tip is, please ma’am, and please Sir, don’t try to walk three and four people across on a busy New York sidewalk. Please leave room for both directions.
W- If you’re going out for a night on the town in New York City, where would you go?

I love sending people to Liberty Island or at least on the Ferry to ride by the Statue. I love sending the family to New Jersey to look at NYC from the other side of the river. I just love the lights.

Williams- I really think seeing Some Like It Hot would be an amazing night out in New York City. I love anything that allows me to escape, be happy, and learn new things.
W- Where are your favorite spots to send
W- What is your favorite meal to enjoy in New York City?

Williams- My favorite meal is a seafood Boil at Aqua Boil or a Killer Bee Pizza from Side.




Comprised of Times Square, the Theatre District and points west, Midtown West spans 59th St. to 42nd St. Highlights include Rockefeller Center, Radio City Music Hall, home of the world-famous Rockettes and the Rainbow Room. One of New York’s classic restaurants, the Rainbow Room, reopened back in 2014 after undergoing a significant renovation. The new space features a touch of modernity without losing any of its character.
Located at Rockefeller Center is NBC Studios, where visitors and locals can be part of the studio audiences for some of their favorite talk shows like “Late Night with Seth Meyers” and “The Tonight Show Starring Jimmy Fallon.”
Three blocks north you’ll find the world-famous Museum of Modern Art Constantly featuring various exhibits and events, MoMA never fails to deliver something interesting on any given day.
Heading farther west is Hell’s Kitchen. Known initially as a crime-heavy neighborhood pre-gentrification, Hell’s Kitchen began life as a haven for working-class Irish Americans. The bustling neighborhood is now most known for Restaurant Row, located on 46th St. Home to many established restaurants, this culture-heavy street has something for all palates. Hell’s Kitchen isn’t only known for its delicious eateries.
In the latter half of the 20th century, Hell’s Kitchen grew in popularity because of its proximity to Broadway theaters and the Actors Studio. The cost of living at the time was low, making the unpopular neighborhood a hot choice for aspiring actors and artists.
The extreme western edge by the Hudson River boasts the famous WWII aircraft carrier, now the Intrepid Sea, Air & Space Museum, as well as the famous Circle Line sightseeing boats. Make sure to check online in advance for daily tour reservations.
Times Square stretches from 40th St. to 53rd St. between 8th Ave. and Broadway, at the heart of the Theater District. The Theater District is home to 41 professional theaters and hosts some of the most popular Broadway performances.
Times Square got its title when The New York Times moved into the area back in 1904. Nowadays, the area is known for many of New York’s key tourist attractions that are fun for the whole family. These include Madame Tussauds, Dave and Buster’s and Spyscape.
If you make your way to the northern section of Times Square, you’ll find yourself at the Red Stairs at 47th St. and Broadway—the perfect place for a selfie, and the spot to see the famed TKTS ticket board. Get deals on same-day Broadway tickets—up to 50% off some of the biggest shows on Broadway (many new shows are opening this year). If you’re looking for sweets, Hershey’s Chocolate World and M&M’s World can be found a block north of the Red Stairs, stocking chocolates, sweets, collectibles, fun gifts and souvenirs.
If you find that you’ve spent so much time in Times Square that midnight is now upon you, relax, you’re in the right place at the right time. Every night, beginning three minutes to midnight, Times Square has its Midnight Moment. This display is
the world’s largest, longest-running digital art exhibition, synchronized on all the electronic billboards throughout Times Square. It’s quite a sight to see and you won’t want to miss it.
Like the Midnight Moment, if you’re in New York City around New Year’s Eve, don’t miss the Times Square ball drop—a must-see, at least once in a lifetime. With over a million annual visitors, it’s like a massive party at the heart of the City That Never Sleeps and a testament to the statement that Times Square is the “crossroads of the world.”
Spanning from 5th Ave. to the FDR Drive and from 59th St. to 42nd St., Midtown East is right near the buzz of Times Square. Not to be outshined by Manhattan’s famous city center, Midtown East boasts a variety of attractions that you won’t find anywhere else in New York City.
Located right at the heart of Midtown East is Grand Central Terminal
This New York City landmark is flooded by daily waves of people going to and from the city. Not just a transportation hub, Grand Central is also a center for dining, shopping and culture. The iconic location has 60 shops, 35 places to eat and many pieces of magnificent architecture, including a beautiful astronomical
ceiling and the whispering arches. Steps away from Grand Central Terminal is Summit One Vanderbilt See New York City from a new perspective through glass ledges and elevators and “Air” by Kenzo Digital.
On Fifth Ave., two avenues west of Grand Central, is Bryant Park, a perfect spot to sit and rest while watching, or joining, many of the daily events that take place. In the wintertime, the main attractions at the park are the skating rink and the Holiday Shops, while in other seasons, the main attractions are the lawn, where movie nights and yoga sessions take place, and the game spots, hosting activities such as Ping Pong and Kubb. Located at the east end of the park is the iconic New York Public Library, home to over 10 million books.
Going up Fifth Ave., you’ll find St. Patrick’s Cathedral on 50th St., a 339-foot-tall cathedral that is home to many religious works of art, musical instruments and architecture that never ceases to impress.
Continue north, and you’ll find yourself strolling through one of the most glamorous shopping districts in the city, which hosts Saks Fifth Avenue, Bergdorf Goodman, Tiffany & Co. and other high-end stores. Here you can window shop to your heart’s content or (if you have the budget) even walk around some of
the world’s most renowned retailers in New York City for some retail therapy.
Going to the FDR Dr. on the other side of Midtown East is the globally recognized United Nations from 48th St. to 42nd St. With an art collection that could rival some of New York City’s most stunning museums, this location is an international landmark worth seeing. Four different tours are offered—check online for reopening tour dates.
Central Midtown boasts a few major sites of its own, including the famous Empire State Building. This building is a National Historic Landmark. Built in just 410 days, it is 102-stories high and has marvelous views of the city from above.
If you wait until dark, make sure to look at what color the Empire State Building is sporting. They change daily based on what holidays or commemorative events are happening. For a more adult experience, the Museum of Sex is located just a few blocks down from the Empire State Building.
Also in Central Midtown is the enormous Macy’s flagship store. Sitting on one entire city block, it is one of the largest (and most famous) department stores in the world.


The Upper West Side starts at Columbus Circle, where Broadway meets 59th St., 8th Ave., Central Park South and Central Park West. This mesh of streets join to form Columbus Circle. The Time Warner complex here houses some of the most exquisite shops in the city and Jazz at Lincoln Center—a concert venue that always has a fantastic jazz line-up. One of the largest cultural complexes in the world is also nearby on 63rd St. and Columbus Ave. Lincoln Center is an impressive and sleek set of buildings that house some of the most remarkable arts and entertainment in the city, including the Metropolitan Opera, the New York City Ballet and the New York Philharmonic.
Farther uptown, you can purchase timed tickets to visit the famous American Museum of Natural History. The massive hanging whale, the largest dinosaur skeleton of the Titanosaur and the state-of-the-art Rose Center for Earth and Space, locally known as The Planetarium, are not to be missed. Right next door, fanatics of history will be delighted to find the New York Historical Society Museum. Going up along Amsterdam Ave., you’ll be able to see for yourself why the Avenue is known for its abundance of truly outstanding restaurants—make sure to stop in at one or two on your trip.
Starting around 110th Street, you’ll find yourself in Morningside Heights, home to the Jewish Theological Seminary, Columbia University and Barnard College campuses. See the breathtaking St. John the Divine and make sure to take some photos in front of Tom’s restaurant, the famous site of Monk’s diner from the hit sitcom “Seinfeld”—two must-see locations in the Upper West Side and Morningside Heights. Grant’s Tomb is just a few blocks away as well, so be sure to make a stop there.
You can get a carriage ride at the 59th Street end of the park. These rides can last either 20 minutes or 45 minutes, and your friendly guide will provide facts about Central Park throughout the trip. These horsedrawn carriages are a perfect way to start or end a visit to Central Park.
One of the many sites in the park includes the Central Park Zoo Located on 64th St. and 5th Ave., the zoo is home to leopards, red pandas, snow monkeys, grizzly bears, sea lions and many more animals. It’s a perfect place to spend an afternoon.
Toward the middle of the park, in the area between 72nd St. and 84th St., you will come upon Strawberry Fields, a beautiful memorial dedicat-
ed to the late Beatle, John Lennon— musician and peace activist. Right next to Strawberry Fields is The Dakota. Built in 1884, The Dakota is considered one of Manhattan’s most luxurious residential buildings and was at one point home to John Lennon from 1973 until his death in the building’s archways in 1980.
Upper East Side/Yorkville Blocks of elegant mansions and townhouses characterize the Upper East Side, once known as the Silk Stocking District, because all the city’s wealthiest and most powerful people lived there, especially along Park, Madison and Fifth Avenues. This neighborhood continues to be some of the most coveted real estate in New York City.
The area starting above 82nd St. and Fifth Ave., going up to 105th St., is known as Museum Mile. This beautiful stretch along Central Park is where you can find the Metropolitan Museum of Art, the Solomon R. Guggenheim Museum, El Museo del Barrio, the Museum of the City of New York, the Jewish Museum, the Cooper Hewitt National Design Museum, the Frick Collection and the Neue Galerie. Any of these fine museums and galleries would make a nice day trip. On 83rd St. is the last remaining original luncheonette in New York City, the Lexington
Candy Shop. This sweet shop is a reminder of a bygone era where soda fountains and luncheonettes were staples in all New York City neighborhoods. If you want to grab even more sweets, head downtown to Dylan’s Candy Bar between 60th St. and 61st St.
A few blocks over is Gracie Mansion, designated the official residence of the Mayor of New York. Due to the pandemic, you can take a virtual tour of its newest exhibits. This house is intended to serve as a “People’s house,” a title that set a standard for the municipality and public access at the time of the building’s original conception.
Take a trip to the top of Manhattan, to Washington Heights and Inwood. This New York City neighborhood, lying right along the majestic George Washington Bridge, was first settled by the Irish, later by European Jews escaping WWII and finally by the Latino community, making it the perfect place to find authentic Latin dining options.
Start with a visit to Fort Tryon Park, home to The Cloisters, an art museum built from reconstructed medieval Chapels and Abbeys originally brought over from Europe. It is now part of The Metropolitan Museum of Art.
Fort Tryon Park is the highest point in New York City, with incredible Hudson River views. During the Revolutionary War, this park was an active fort and served as a strategic military lookout on the Hudson River. Not too far from the park is Jumel Mansion and the Dyckman House, the last known vestiges from the 1700s. Also, in the Heights, visitors of all ages will delight to see Manhattan’s only lighthouse, the famous (and abundantly adoralbe) Little Red Lighthouse
One last famous spot is the High Bridge, the oldest bridge in New York City. Opened in 1848 as part of the Croton Aqueduct, bringing fresh water into the city and later abandoned, it has since been reopened as a pedestrian walkway over the East River.
Above Washington Heights is Manhattan’s northernmost neighborhood, Inwood. Stretching from Dyckman St. to the North end of Manhattan, its residential streets and river shoreline blend
into the wilderness of Inwood Hill Park Dramatic caves, valleys and ridges left as a result of shifting glaciers can be found throughout.
North of Central Park lies Harlem, a vibrant neighborhood long synony cmous with African- American culture. Today you can find charming brownstones and museums, such as the National Jazz Museum. This museum was conceived in 1995 and is dediated to preserving and celebrating Harlem’s jazz history.
If you’re looking for a different kind of cuisine, stop by Minton’s, the birthplace of bebop, a type of jazz. During the 1940s, anyone who was a part of the world of jazz made their way to Minton’s. Artists like Duke Ellington, Louis Armstrong and Ella Fitzgerald performed here. The food is southern comfort style, with classics such as shrimp and grits.
Harlem is one of the best places in the city to find delicious food, and other incredible restaurants include the popular Red Rooster, Sylvia’s Queen of Soul Food, Dinosaur Bar-B-Que and Amy Ruth’s, a restaurant that boasts 14 different takes on chicken and waffles.
Nowadays, when one thinks about the Financial District, the first thing that comes to mind is the World Trade Center. This stunning and beautiful building commemorates the victims of 9/11. The National September 11 Memorial and Museum consists of its famous museum depicting the 9/11 events as well as a beautiful outdoor memorial featuring two enormous waterfalls and reflecting pools. Each pool is about an acre in size, and both pools are set within the footprints of the original Twin Towers. The 9/11 Tribute Center is an additional stopping point to get a more in-depth look at 9/11, its aftermath and the tragic event’s impact on the entire nation from that day forward.
For visitors and locals that want to get an incredible birdseye view of Manhattan, One World Observatory is the place to go. The tower also provides a stunning overhead view of the reflecting pools below. Other great views can be had from the river via Hornblower Cruises at the Statue of Liberty and Ellis Island






Reached by boat from Battery Park, the statue stands tall and proud as a symbol of liberty, while Ellis Island, once a gateway into the United States and at point the biggest immigration inspection one station, is now a museum. Find records of possible family members who passed through or just appreciate the history.
Back on land are Westfield and Brookfield Place. These complexes house shops, restaurants and even an outdoor ice skating rink in the wintertime. One of the eatery highlights at Brookfield Place is Le District—a French-inspired marketplace. Across the street from Brookfield Place, you can find the beautiful Irish Hunger Memorial. The memorial commemorates the Great Irish Famine and is a reminder “that hunger today is often the result of lack of access to land.” Nearby on the west side, you’ll find the Museum of Jewish Heritage: A Living Memorial to the Holocaust. This museum is fully dedicated to the Holocaust and other events of WWII.
Right up the street from this memorial is the Charging Bull statue. This statue took over two years to complete and weighs over three and a half tons.
Walk a few blocks north to view the New York Stock Exchange, where brokers and traders are constantly buying and trading stocks. Across the street is Federal Hall National Memorial. Built in 1842 as the United States Custom House, on the site of the old Federal Hall. It later served as a sub-Treasury building and is now operated by the National Park Service. Imagine standing in the very spot where George Washington did! The Federal Reserve is two blocks up and has special Gold tours of its vaults.
Heading eastward is Seaport District
This Manhattan location features some of the oldest architecture downtown, which includes renovated mercantile buildings, sailing ships, restaurants and shops. The streets here are mostly cobblestone. At the most southern tip of Manhattan is the Staten Island Ferry. From here, you can take a ferry to Staten Island for free (it has excellent views of the Statue of Liberty!). Ferries depart every half hour.
Over many years, Tribeca, which stands below Canal Street, has become a coveted neighborhood full of art galleries
and sophisticated restaurants. Knownfor its low crime rates and excellent public schools, Tribeca is a very residential area, home to many celebrities and wealthy New Yorkers.
Tribeca is also home to some of the best architecture in New York City. You can find the “Jenga” building here (56 Leonard St.) or walk down Staple Street to see the skybridge. It is often debated as to how Staple Street got its name, but what isn’t frequently discussed is that Staple Street is one of New York’s smallest streets, running a mere two blocks.
New York’s Chinatown is located not far from Little Italy, with a booming Asian community. When in Chinatown, take a more scholastic approach to Chinese culture and visit the Museum of Chinese in America. This museum gives an in-depth look into the lives of Chinese- Americans and the role that they played in American culture, as well as the history of their journey to the United States—all done through the museum’s various exhibits. A place more centric to Chinatown worth visiting is Canal Street. Chinatown’s Canal Street has the feel of an open-air bazaar. Here you can bargain for unique products among an impossibly large assortment of all kinds of items.
If you get tired of shopping, make your way to The Original Chinatown Ice Cream Factory. This “family-owned business adds a unique twist to one of America’s favorite desserts by introducing new Chinese-influenced flavors to this cold treat.”
Take a peek at Columbus Park. This historically significant park is in the heart of Chinatown by Baxter St., and Bayard St. Parts of the park are filled with card players and masters of Mahjong, and other parts of the park are often filled with people practicing tai chi and kung fu in open spaces.
Little Italy borders Chinatown. This section is another extremely cultural part of the city. Initially, Little Italy was a large 30-block section of the Lower East Side. Now it has condensed to a couple of blocks centered around Mulberry Street.
the world’s largest, longest-running digital art exhibition, synchronized on all the electronic billboards throughout Times
Square. It’s quite a sight to see and you won’t want to miss it.
Like the Midnight Moment, if you’re in New York City around New Year’s Eve, don’t miss the Times Square ball drop—a must-see, at least once in a lifetime. With over a million annual visitors, it’s like a massive party at the heart of the City That Never Sleeps and a testament to the statement that Times Square is the “crossroads of the world.”
Spanning from 5th Ave. to the FDR Drive and from 59th St. to 42nd St., Midtown East is right near the buzz of Times Square. Not to be outshined by Manhattan’s famous city center, Midtown East boasts a variety of attractions that you won’t find anywhere else in New York City.
Located right at the heart of Midtown East is Grand Central Terminal
This New York City landmark is flooded by daily waves of people going to and from the city. Not just a transportation hub, Grand Central is also a center for dining, shopping and culture. The iconic location has 60 shops, 35 places to eat and many pieces of magnificent architecture, including a beautiful astronomical ceiling and the whispering arches. Steps away from Grand Central Terminal is Summit One Vanderbilt See New York City from a new per-
spective through glass ledges and elevators and “Air” by Kenzo Digital.
On Fifth Ave., two avenues west of Grand Central, is Bryant Park, a perfect spot to sit and rest while watching, or joining, many of the daily events that take place. In the wintertime, the main attractions at the park are the skating rink and the Holiday Shops, while in other seasons, the main attractions are the lawn, where movie nights and yoga sessions take place, and the game spots, hosting activities such as Ping Pong and Kubb. Located at the east end of the park is the iconic New York Public Library, home to over 10 million books.
Going up Fifth Ave., you’ll find St. Patrick’s Cathedral on 50th St., a 339-foot-tall cathedral that is home to many religious works of art, musical instruments and architecture that never ceases to impress even the harshest of critics.
Continue north, and you’ll find yourself strolling through one of the most glamorous shopping districts in the city, which hosts Saks Fifth Avenue, Bergdorf Goodman, Tiffany & Co. and other high-end stores. Here you can window shop to your heart’s content or (if you have the budget) even walk around some of the world’s most renowned retailers in New York City for some retail therapy.
Going to the FDR Dr. on the other side of Midtown East is the globally recognized United Nations from 48th St. to 42nd St. With an art collection that could rival some of New York City’s most stunning museums, this location is an international landmark worth seeing. Four different tours are offered—check online for reopening tour dates.
Central Midtown boasts a few major sites of its own, including the famous Empire State Building. This building is a National Historic Landmark. Built in just 410 days, it is 102-stories high and has marvelous views of the city from above.
If you wait until dark, make sure to look at what color the Empire State Building is sporting. They change daily based on holidays or commemorative events. For a more adult experience, the Museum of Sex is located a few blocks from the Empire State Building.
Also in Central Midtown is the enormous Macy’s flagship store. Sitting on one entire city block, it is one of the largest (and most famous) department stores in the world.
Head past the park to the area where MacDougal St. meets Bleecker St., and you’ll find yourself in a sea of fantastic music venues,


comedy clubs and restaurants. Here you can find numerous venues where many of the world’s famous performers such as Jimi Hendrix and Bob Dylan performed.
You can also stop at Caffe Reggio—the first U.S. cafe to serve a cappuccino back in 1927. Just down the block away is the Comedy Cellar, where numerous big-time comedians stop by to test out new material.
You can find the East Village east of the Bowery between Houston St. and 14th St., where Manhattan extends to the East River, and the avenues start going by letters instead of numbers. Despite the passing of time, the East Village still retains all of the grit for which it was once known.
The East Village is most known for its nightlife, bars and food locations. St. Marks is a wonderful nightlife hub in itself, with several bars, restaurants and dessert locations lining 8th St. between 3rd Ave. and 2nd Ave. The area is also home to Barcade. This is also where you’ll find La MaMa Experimental Theater Club, which has been one of New York City’s most respected experimental theater companies since the 1960s. When it comes to museums, the East Village is sparse, but the Museum of the
Right in the center of the East Village is Tompkins Square Park, a quaint and small park at the center of this eclectic neighborhood. The park hosts numerous performances that are as diverse as the people that live in the East Village: the outdoor drag festival Wigstock, the Howl Festival commemorating Allen Ginsberg and the Charlie Parker Jazz Festival.
Although the East Village has many great bars, one of its best-known spots for drinks (and a lot of history) is McSorley’s Old Ale House. This old-time pub was established in 1854 and serves only light or dark ale. Come here for the nostalgia and the sawdust found on the floors.
The small slice of Manhattan that runs from Gansevoort St. to West 14th St. and from Hudson St. to the Hudson River has grown quickly over the years into one of Manhattan’s most glamorous neighborhoods. Starting in the 1900s, the Meatpacking District was primarily composed of meatpacking plants but has evolved into a bustling hive of late-night hot spots, hotels and nightclubs.
Take a stroll on the High Line, which
starts at the base of the neighborhood. The High Line was built as a railroad to deliver products to buildings along the route. One interesting fact about the area: the Meatpacking District was actually the birthplace of the Oreo Cookie. For a fun coffee experience, make a visit to the Starbucks Reserve Roastery
Visit the Whitney Museum of American Art. This modern and culturally charged art museum also has excellent outdoor views of the West Village and the Hudson River. If you’re looking for other great views, go to the Top of the Standard
Union Square has long been a center for political demonstrations, starting in 1861 with the Great Sumter Rally and later hosting labor union rallies, Occupy Wall Street protesters and serving as a gathering point for those mourning the 9/11 attacks. Stretching from 14th St. to 17th St. and from Union Square West to Union Square East, the lush greenery of Union Square makes it perfect for gatherings. On Mondays, Wednesdays, Fridays and Saturdays, this location hosts the Union Square Greenmarket. Browse for fresh produce, flowers and more alongside New York City’s top chefs shopping for ingredients for their next culinary masterpiece.
Madison Square Park sits in the Flatiron District from 23rd St. to 26th St., between Madison Ave. and Fifth Ave. It is a perfect spot to stop for lunch or to get an amazing view of the Flatiron Building— the iconic triangular building completed in 1902—from the park. Right next to Madison Square Park, you can take a trip through Eataly, an Italian marketplace with various restaurants, cooking demonstrations, pantry items for sale and bakeries. The marketplace makes its home in the magnificent Toy Center Building, which was once headquarters to just about every famous toy manufacturer but has since been converted into residential spaces and luxury shopping options.
Three Michelin star restaurant Eleven Madison Park returned to its acclaimed location inside the Met-Life Building in June of this year. Chef Daniel Humm will not be bringing back his iconic meat-forward dishes and has confirmed that the restaurant will now be offering a new vegan menu.
Another great park in the Flatiron district is Gramercy Park—a park developed in the 1830s to resemble a London Square. If you do go to see Gramercy Park, don’t expect to go inside the park. The most you can do is look at it from the outside since you need a very exclusive key to enter the park. There are currently around 400 keys in rotation, and only residents of the Gramercy Park area have them. The locks are changed out yearly.
Fotografiska New York aims to inspire a more conscious world through the power of photography. Founded in Stockholm in 2010, Fotografiska opened its newest outpost in the treasured, six-floor historic building in the Flatiron District.
Chelsea can be found north of the West Village between 14th St. and 29th St. This part of Manhattan was once an industrial area but has since been developed into a highly coveted residential area.
With over 200 gallery spaces (including the Gagosian), Chelsea is the perfect place to wander through some of the best art in New York City.
Right underneath the High Line, which starts in the Meatpacking District, on 15th St., you can find Chelsea Market, which is known as a food emporium of
sorts. You can get just about anything from delicious fresh lobster to milk from a milk bar. Shoppers can find something for everyone at Chelsea Market.
A little farther up is Chelsea Piers. Chelsea Piers is most known for its golfing range, but the sports complex has an entire menu of activities from which to select. These include ice skating, basketball and even rock climbing. There’s an activity for everyone here.
Located on 17th St. between 7th Ave. and 6th Ave., you can find the Rubin Museum of Art. This museum is dedicated to the preservation of the art and cultures of the Himalayas, India and neighboring regions. The museum is built in the shape of a tower, where each floor’s design gives the feel of climbing a mountain; the bottom floor is the base of the mountain, and the top floor is at the peak, way above the clouds.
If you’re looking for a truly exciting evening, and if there is a specific show or game that you’re interested in seeing, then Madison Square Garden is the place to be. The venue is known as “The World’s Most Famous Arena” for a good reason.
Set atop rail yards, Hudson Yards is altering the Hudson River skyline with its rising skyscrapers. New York’s newest neighborhood is home to more than 100 shops and delicious culinary experiences featuring restaurants from celebrity chefs like David Chang and José Andrés. If you’re in search of the perfect sweet treat or souvenir, you’re sure to find it here. Hudson Yards is also home to the city’s first Neiman Marcus, public art and dynamic cultural institutions, including The Shed, and 14 acres of public plazas, gardens, groves and the world’s first Equinox Hotel®.
Hudson Yards is another ideal location to spend an afternoon or an entire day. Visit various shops and enjoy numerous dining outlets. Last but not least, make a visit to The Edge. With a one-of-a-kind design, The Edge is suspended in mid-air, giving you the feeling of floating in the sky with 360-degree views. Have a look 100 stories down from the glass floor and lean out over the city for a view while resting on angled glass. Experience New York City from up high in the clouds at The Edge.



















Rideshare has become increasingly popular all around the country, and it’s no different in NYC. Remember that surge pricing can be unpredictable and shorter rides can still be fairly costly. Be prepared and plot alternatives just in case.
The New York City subway system is the largest of its kind in the United States, with over 24 lines and 472 stations. Over five million passengers ride it daily. The subway is perfect for quick stops and longer rides all the way across town.
The iconic yellow cab is one of the oldest and most popular ways to get around NYC. All you need to do is hail one on the street corner or use an app like Curb to call one or schedule a pick-up for events or easy trips to the airport.
The ferry system in New York is one of the oldest forms of transportation in the city. Today, these ferries span multiple waterways, including the Hudson River, East River, and Staten Island Ferry;, allowing passengers to access various boroughs.
For those looking for a bit more adventure while exploring the city’s many sights and sounds, consider taking advantage of Citi Bike—New York’s own bicycle sharing program, complete with thousands of bikes located all over Manhattan.
Public buses in New York offer convenient and low-cost transportation for tourists and locals alike.
With over 5,800 vehicles operating 24/7 across the five boroughs, these bus routes provide easy access to attractions and neighborhoods.

There are plenty of ways to navigate the concrete jungle and numerous modes of transportation to get you from point A to point B. While the city is certainly walkable, we often need a little extra help getting around. New York City is known for its bustling streets, unique attractions, and diverse culture. For visitors and locals alike, getting around the city is a breeze with its wide array of transportation options. New Yorkers and travelers have access to a multitude of choices when it comes to moving throughout their busy urban landscape.
From taxi cabs and ride-shares to public buses, subways, ferries and even bike share systems, navigating the five boroughs has never been easier or more convenient. Whether you’re traveling from uptown to downtown or from one side of the city to another, there’s an option for everyone.


& Juliet (Musical)Stephen Sondheim Theatre, 124 W. 43rd St., 212.719.1300, AndJulietBroadway.com
Aladdin (Musical)- New Amsterdam Theatre, 214 W. 42nd St., 866.870.2717, AladdinBroadway.com
Bad Cinderella (Musical)- Imperial Theatre, 249 W. 45th St., 212.239.6200, BadCinder ellaBroadway.com
A Beautiful Noise, The Neil Diamond MusicalBroadhurst Theatre, 235 W. 44th St., 212.239.6200, ABeautifulNoiseTheMu sical.com
Camelot (Play, Previews 03/09)- Vivian Beaumont Theater, 150 W. 65th St., 212.501.3100, LCT.org
CHICAGO (Musical)- Ambassador Theatre, 219 W. 49th St., 212.239.6200, ChicagoTheMusical.com
Dancin’ (Musical, Previews 03/02)- Music Box Theatre, 239 W. 45th St., 212.239.6200, DancinBway.com
A Doll’s House (Play)Hudson Theatre, 139-141 W. 44th St., 855.801.5876, ADollsHouseBroadway. com
Fat Ham (Play, Previews 03/21)- American Airlines Theatre, 227 W. 42nd St., 212.719.1300, FatHam Broadway.com
Funny Girl (Musical)- August Wilson Theatre, 245 W. 52nd St., 888.985.9421, FunnyGirlOnBroadway. com
Good Night, Oscar (Play, Previews 04/07)- Belasco Theatre, 111 W.
44th St., 212.239.6200, GoodNightOscar.com
Hadestown (Musical)Walter Kerr Theatre, 219 W. 48th St., 212.840.0479, Hadestown.com
Hamilton (Muscal)- Richard Rodgers Theatre, 226 W. 46th St., 212.221.1211, hamiltonbroadway.com
Harry Potter and the Cursed Child (Play)- Lyric Theatre, W. 43rd St., 877.250.2929, harrypottertheplay.com
Kimberly Akimbo (Comedy)- Booth Theatre, 222 W. 45th St., 212.239.6200, KimberlyAkimboTheMu sical.com
Leopoldstadt (Play)- Longacre Theatre, 220 W. 48th St., 212.239.6200, LeopoldstadtPlay.com
Life of Pi (Play, Previews 03/09)- Gerald Schoenfeld Theatre, 236 W. 45th St., 212.239.6200, LifeOfPiBway.com
The Lion King (Musical)Minskoff Theatre, 1515 Broadway, 212.869.0550, lionking.com
MJ THE MUSICAL- Neil Simon Theatre, W. 52nd St., 212.757.8646, MJTheMusical.com
MOULIN ROUGE! THE MUSICAL!- Al Hirschfeld Theatre, 302 W. 45th St., 212.840.0479, MoulinRougeMusical.com
New York, New York (Musical, Previews 03/24)- St. James Theatre, 246 W. 44th St., 888.985.9421, NewYorkNewYorkBroadway.com
Parade (Play)- Bernard B. Jacobs Theatre, 242 W. 45th St., 212.239.6200, ParadeBroadway.com
Peter Pan Goes Wrong (Play, Previewing 03/17)- Ethel Barrymore Theatre, 243 W. 47th St., 212.239.6200, PanGoes WrongBway.com
The Phantom of the Opera (Musical, Closes 04/16)- Majestic Theatre, 245 W. 44th St., 212.239.6200, thephanto moftheopera.com
Pictures From Home (Play)- Studio 54, 254 W. 54th St., 212.719.1300, PicturesFromHome Broadway.com
Prima Facie (Play, Previews 04/11)- John Golden Theatre, 252 W. 45th St., 212.239.6200, PicturesFromHome Broadway.com
Room (Play, Previews 04/03)- James Earl Jones Theatre, 138 W. 48th St., 212.239.6200, Room Broadway.com
Shucked (Musical, Previews 03/08)- Nederlander Theatre, 208 W. 41st St., 212.921.8000, ShuckedMusical.com
SIX-THE MUSICALBrooks Atkinson Theatre, 256 W. 47th St., 212.719.4099, SixTheMusical.com
Some Like It Hot (Musical)- Sam S. Shubert Theatre, 225 W. 44th St., 212.239.6200, Some LikeItHotMusical.com
Summer, 1976 (Play, Previews 04/04)- Samuel J. Friedman Theatre, 261 W. 47th St., 212.399.3000, ManhattanTheatreClub. com
Sweeney Todd (Musical)- Lunt-Fontanne Theatre, 205 W. 46th St., 212.575.9200, Sweeney ToddBroadway.com
The Thanksgiving Play (Play, Previews 03/23)Helen Hayes Theatre, 240 W. 44th St., 212.541.4516, 2st.com
Wicked (Musical)- Gershwin Theatre, 222 W. 51st St., 212.586.6510, wickedthemusical.com
1+1- Soho Playhouse, 15 Vandam St., 212.691.1555, sohoplayhouse.com
According to the Chorus (Previews 03/23)- 59E59 Theater C, 59 E. 59th St., 212.753.5959, 59e59.org
The Best We Could (a family tragedy)- Manhattan Theatre ClubStage I, 131 W. 55th St., 212.399.3000, manhattan theatreclub.com
black odyssey- Classic Stage Company, 136 E. 13th St., 212.677.4210, classicstage.org
Blue Man Group- Astor Place Theatre, 434 Lafayette St., 212.254.4371, blueman.com
Brainsmash (Previews 03/02)- 59E59 Theater C, 59 E. 59th St., 212.753.5959, 59e59.org
A Bright New BoiseThe Pershing Square Signature Center/Irene Diamond Stage, 480 W. 42nd St., 212.244.7529, signaturetheatre.org
Cat on a Hot Tin RoofTheatre at St. Clement’s, 423 W. 46th St., 212.246.7277, stclementsnyc.org
The Coast StarlightMitzi E. Newhouse Theater, 150 W. 65th St., 212.501.3100, lct.org
Cornelia Street- Atlantic






























































































































































































4th St., 220 E. 4th St., 646.343.1584, connelly theater.org
212.315.2302, westsi detheatre.com






The Great Gatsby (Previews 03/09)- Park Central Hotel, 870 7th Ave., 212.247.8000, parkcentralny.com
Love- Park Avenue Armory, 643 Park Ave., 212.616.3930, armoryon park.org






















The Half-God Of Rainfall- New York Theatre Workshop, 79 E. 4th St., 212.780.9037, nytw.org
Lucy- Minetta Lane Theatre, 18 Minetta Ln., 800.745.3000
Misty (Previews 03/03)The Shed, 545 W 30th St., 646.455.3494, theshed.org









































The Harder They ComePublic Theater/Newman Theater, 425 Lafayette St., 212.539.8500, publictheater.org
Murdered by the MobThe Secret Room, 707 8th Ave., 917.708.8663, secretroomnyc.com

Dark Disabled StoriesPublic Theater/Shiva Theater, 425 Lafayette St., 212.539.8500, pub lictheater.org
Crumbs From The Table Of Joy- Theatre Five @ Theatre Row, 410 W. 42nd St., 212.714.2442, theatrerow.org
Dog Man The Musical (Previews 03/04)- New World Stages Stage 3,















Theater Company/Stage 2, 330 W. 16th St., 212.691.5919, atlanticthe ater.org
David Blaine Presents Asi Wind’s Inner CircleThe Gym at Judson, 243 Thompson St., 866.811.4111, thegymat judson.com
Día Y Noche (Previews 03/18)- 59E59 Theater B, 59 E. 59th St., 212.753.5959, 59e59.org

How To Defend Yourself- New York Theatre Workshop, 79 E. 4th St., 212.780.9037, nytw.org








340 W. 50th St., new worldstages.com
Dueling Pianos- The Cutting Room, 44 E. 32nd St., 212.691.1900, thecutting roomnyc.com
Elyria- Atlantic Theater Company/Linda Gross Theater, 336 W. 20th St., 212.691.5919, atlanticthe ater.org
Endgame- Irish Repertory Theatre, 132 W. 22nd St., 212.727.2737, irishrep. org
Fall River Fishing- Connelly Theatre, 220 E. 4th St., 646.343.1584, connel lytheater.org
Gazillion Bubble ShowNew World Stages Stage II, 340 W. 50th St., newworldstages.com
The Good John Proctor (Previews 03/11)- Connelly Theatre, 220 E.
The Imbible: A Spirited History of Drinking- New World Stages Stage IV, 340 W. 50th St.,newworldstages.com
The Imbible: Day Drinking- New World Stages Stage I, 340 W. 50th St., newworldstages.com
Improv 4 Kids- Broadway Comedy Club, 318 W. 53rd St., 212.757.2323, broadwaycomedyclub. com
The Infinite WrenchKraine Theatre, 85 E. 4th St., 212.777.6088, frigid. nyc
Katsura Sunshine’s Rakugo- New World Stages Stage II, 340 W. 50th St., newworldstages.com
Letters From Max- The Pershing Square Signature Center/Alice Griffin Jewel Box Theatre, 480 W. 42nd St., 212.244.7529, signaturetheatre.org
Little Shop of HorrorsWestside Theatre (Upstairs), 407 W. 43rd St.,
The Office! A Musical Parody- The Theater Center/ The Jerry Orbach Theater, 210 W. 50th St., 212.921.7862, thetheater center.com
Perfect Crime- The Theater Center/ Anne L. Bernstein Theater, 210 W. 50th St., 212.921.7862, thetheatercenter.com
The Play That Goes Wrong- New World Stages Stage IV, 340 W. 50th St., newworldstages.com
Regretfully, So the Birds Are (Previews 03/22)Playwrights Horizons/ Peter Jay Sharp Theater, 416 W. 42nd St., 212.564.1235, playwright shorizons.org
Sancocho (Previews 03/11)- WP Theater, 2162 Broadway, 212.765.1706, wptheater.org
Shedding Load- 59E59 Theater C, 59 E. 59th St., 212.753.5959, 59e59.org
The Sign in Sidney Brustein’s WindowBrooklyn Academy of Music - Harvey Theatre, 651 Fulton St., 718.636.4100, bam.org
Sleep No More- The McKittrick Hotel, 530 W. 27th St., 212.904.1883, http://www.mckittrickhotel.com/
Speakeasy Magick- The McKittrick Hotel, 530 W. 27th St., 212.904.1883, http://www.mck ittrickhotel.com/
Three Sisters- New York Theatre Workshop, 79 E. 4th St., 212.780.9037, nytw.org
Titanique: Une Parodie MusicaleDaryl Roth Theatre, 101 E. 15th St., 212.375.1110, darylroththeatre.com
The Trees- Playwrights Horizons/ Mainstage Theater, 416 W. 42nd St., 212.564.1235, playwrightshori zons.org
Vanities—The Musical (Previews 03/22)- Theater at St. Jean’s, 150 E. 76th St., 212.288.5082, sjbny.org
The Very Hungry Caterpillar Show- DR2 Theatre, 103 E. 15th St., 212.375.1110, darylroththeatre.com
The Wanderers- Roundabout Theatre Company - Laura Pels Theatre, 111 W. 46th St., 212.719.1300, roundabouttheatre.org
White Girl In Danger (Previews 03/15)- Tony Kiser Theatre, 305 W. 43rd St., 212.541.4516, 2st.com
Without You (Closes 04/30)- New World Stages Stage 1, 340 W. 50th St., 646.871.1730, newworldstages. com
Yes, I Can Say That! (Previews 03/04)- 59E59 Theater A, 59 E. 59th St., 212.753.5959, 59e59.org
DANCE + MUSIC
Carnegie Hall- 57th St. and 7th Ave., 212.247.7800, carnegie hall.org
Metropolitan Opera- Metropolitan Opera House, Columbus Ave., btw W. 63rd St. & W. 64th St., 212.362.6000, metopera.org
Joyce Center- 175 8th Ave., at W. 19th St., 212.242.0800, joyce.org
Distinguished Concerts Interna tional- Carnegie Hall, Seventh Ave., at W. 57th St., 212.247.7800, brdciny.com
New York PhilharmonicGeffen Hall at Lincoln Center, Columbus Ave., at W. 64th St., 212.875.5656, nyphil.org
The Bitter End- 147 Bleeker St., 212.673.7030, bitterend.com
Brooklyn Bowl- 61 Wythe Ave., 718.963.3369, brooklynbowl.com
Cafe Wha?- 115 MacDougal St., 212.254.3706, cafewha.com
Dizzy’s Club Coca-Colabus Cir., Broadway & W. 60th St., 212.258.9595, jazz. org/dizzys
Village Vanguard- 178 Seventh Ave. So., 212.255.4037, villagevanguard.com
Barclays Center- 620 Atlantic Ave., at Flatbush Ave., Brooklyn, 800.745.3000, barclayscenter.com
Beacon Theatre- 2124 Broadway, at W. 74th St., 866.858.0008, msg. com/beacon-theatre
Madison Square Garden866.858.0008, msg.com/ madi son-square-garden
Rockwood Music HallSt., 212.477.4155, rockwoodmusi chall.com
Lavo Nightclub- 40 E. 58th St., 212.584.2700, taogroup.com/ven ues/lavo-italian-restaurant-newyork/
Marquee New York- 289 10th Ave., 646.473.0202, taogroup.com/ven ues/marquee-new-york/
Tao Nightclub- 369 W. 16th St., 212.888.1440, taodowntown.com/ nightclub/





So many places to see, where do you start?
New York CITYPASS- This discount pass provides access to a choice of six major attractions at a saving of 42 percent off regular admissions. Passes are sold online or at participating attractions and are good for nine days from the first day of use. A pass with a choice of three attractions is also available for visitors with limited time or shorter stays. Citypass.com
Go City® New York- Plan your visit based on the number of attractions you’d like to see or the number of days you plan to be in New York City. Explorer Passes come with between two and ten attractions, while All-Inclusive Passes allow you to visit as many attractions as you want in a set amount of days (from one day up to ten days). See as much or as little as you would like during your stay in New York City. Gocity.com
ARTECHOUSE NYC- Marvel at the interactive art in this futuristic space with rotating new exhibits throughout the year. 439 W. 15th St., artechouse.com/location/nyc
Brooklyn Botanic GardenMarvel at the stunning horticultural displays including some of the best cherry blossoms in the city. 990 Washington Ave., 718.623.7200, bbg.org
Bronx Zoo- Visit with over 10,000 animals across over 265 acres. 2300 Southern Blvd., The Bronx, 718.367.1010, bronxzoo.com
Color Factory New YorkExplore the world of color through a series of interactive displays. 251 Spring St., 347.378.4071, colorfactory.co
Edge- With a one-of-a-kind design, the attraction is suspended in mid-air, giving you the feeling of floating in the sky with 360-degree views you can’t get anywhere else. Look 100 stories down from the thrilling glass floor. 30 Hudson Yards, 332.204.8500, Edgenyc.com
Empire State Building- One of the world’s most famous buildings defines the iconic NYC skyline. 20 W. 34th St., 212.2736.3100, esbnyc.com
The FRIENDS ExperienceFans of the sitcom can journey exhibits and recreated sets from the hit show. 130 E. 23rd St., friendstheexperience.com/new-york
Liberty Science Center- Explore a dozen exhibits and a planetarium. 222 Jersey City Blvd., Jersey City, NJ, 201.200.1000, lsc.org
Madame Tussauds New York- Pose with life-size wax models of famous historical figures and celebrities. 234 W. 42nd St., 212.512.9600, madametussauds.com/newyork/
New York Aquarium- The New York Aquarium is the oldest continually operating aquarium in the United States, located on the Riegelmann Boardwalk in Coney Island, Brooklyn. 602 Surf Ave., Brooklyn, 718.265.3474, nyaquarium.com
New York Botanical Garden- Explore miles of beautiful gardens and walking trails, educational programs, free tours, and a hands-on children’s park offer an escape from the city. 2900 Southern Blvd., Bronx, 718.817.8700, nybg.org
One World Observatory- The three-level indoor observatory is at the top of the tallest building in the Western Hemisphere. One World Trade Center, 285 Fulton St., entrance to the observatory is on West St., at Vesey St.,
844.696.1776, oneworldobservatory.com
The Original Chinatown Ice Cream Factory- This “family-owned business adds a unique twist to one of America’s favorite desserts. 65 Bayard St., 212.608.4170, chinatownicecreamfactory.com
RiseNY- Soar over the Big Apple at this new attraction. 160 W. 45th St., 718.701.4998, riseny.co
Sloomoo Institute- This family-friendly space helps children of all ages explore their senses. 475 Broadway, sloomooinstitute.com
Snug Harbor Cultural Center & Botanical Garden- Snug Harbor is a collection of architecturally significant 19th-century buildings on Staten Island, New York City. 1000
Richmond Terrace, Staten Island, 718.425.3504, snug-harbor.org
Statue of Liberty- Visit one of the world’s most famous landmarks with educational guided tours and harbor views. 212.363.3200, nps. gov/stli
SUMMIT One Vanderbilt- The newest observation deck in NYC has plenty to offer. Experience it with glass terraces, an immersive art installation and glass-bottom elevators. 45 E. 42nd St., 877.682.1401, summitov.com
Top Of The Rock- The open-air observation deck welcomes visitors with panoramic vistas 70 floors above street level. 30 Rockefeller Plz., W. 50th St., btw Fifth Ave. & Sixth Ave., 877.692.7625, topoftherocknyc.com

1 2 3 4 5
Central ParkOne of the quintessential experiences you can enjoy in New York City is a visit to Central Park. If you’re visiting anywhere north of Midtown, it’s almost impossible to miss (and you shouldn’t miss it). 212.310.6600, centralparknyc.org
National Museum of the American Indian- This museum is free to visit every day of the week and the National Museum of the American Indian is also part of the Smithsonian Institute. 1 Bowling Green, 212.514.3700, americanindian.si.edu
High LineVenture through the city from 30-feet above for a leisurely stroll. The High Line is a fantastic way to wander the city with great views (it even has its own observation deck) from 30th St. to Gansevoort St. 212.500.6035, thehighline.org
The Morgan Library & MuseumVisit the stunning library and museum on Fridays from 5pm-7pm and admission is free. Just make sure to book your tickets in advance to ensure your entry. 225 Madison Ave., 212.685.0008, themorgan.org
Staten Island Ferry- Viewing the skyline of Manhattan from the water is a great experience and via the Staten Island Ferry, it’s a free one too. The ferry runs 24 hours a day, seven days a week from the Whitehall Ferry Terminal. siferry.com
Osteria Accademia is the newest addition to the Upper West Side dining scene, bringing a taste of Mediterranean flavors to New York City. Led by restaurateurs Huseyin Ozer and Murat Akinci, the restaurant aims to create a cozy atmosphere for locals to enjoy fine Italian cuisine and good conversation in the Big Apple. With its nod to the universities and academies in NYC, Osteria Accademia is sure to be a hit among the intellectual crowd.
646 Amsterdam Ave., 212.685.0305, accademianyc.com
Chef Mirra Sims’ Lafolia Restaurant is one of the most exciting new additions to the New York City food scene. Located on the lower level of The Gardens at 780, this hidden gem has quickly become a favorite among locals for its fresh ingredients and vegetable-forward dishes. The menu features a variety of Italian-inspired dishes, including Heritage Bacon Carbonara and Cippolini Stuffed Flatbread. In addition to the a la carte menu, Lafolia Restaurant also has a lively happy hour.
780 3rd Ave., 607.295.3314, lafolia-nyc.com
Olio e Più
Olio e Più serves up Italian comfort foods for lunch, dinner, weekend brunch and happy hour. The restaurant’s rustic space and spacious sidewalk seating offer the perfect setting for a delicious meal with family and friends. Diners can choose from a wide selection of menu items, including charcuterie boards, homemade pastas and handmade pizzas.
3 Greenwich Ave., 212.243.6546, olioepiu.nyc
Masserie dei Vini serves farm fresh Italian classics from Puglia. The restaurant’s menu contains an extensive selection of antipasti and salads, pastas, pizzas and main courses. Diners can enjoy traditional tastes and more obscure flavors like the “Tartufo Nero” and the “Agnolotti Piemontesi.” Make sure to save room for one of the decadent desserts like the “Crostatina Di Mele Con Gelato Alla Vaniglia.”
887 9th Ave., 212.315.2888, masseriadeivini.com
Enjoy classic Italian cuisine and reimagined flavors at Portale. The restaurant’s open kitchen and neutral color palette provide a serene space while the menu serves up all the best Italian dishes. Dine on traditional items like burrata and polpette (meatballs), or try out new tastes like the “Crudo di Tonno” (yellowfin tuna tartare) and the “Ippoglosso” (halibut). Stop by for happy hour and try out a variety of small plates alongside cocktails and happy hour wine specials by the glass.
126 W. 18th St., 917.781.0255 portalerestaurant.com







Balthazar- This French brasserie serves up French food classics along with contemporary and traditional fare from morning until late. It’s also a New York City staple for a decadent brunch. 80 Spring St., 212.965.1414, balthazarny. com
Brooklyn Chop House Chic- Restaurant/ bar offering American steakhouse fare, Chinese dumplings, Peking duck, and more. 150 Nassau St., 212.619.1200, brooklynchophouse.com
Buddakan- Fans of “Sex and the City” might recognize the stunning dining room at Buddakan as the setting for Carrie Bradshaw’s rehearsal dinner. 75 9th Ave., 212.989.6699, buddakannyc.com
Clinton Hall- Beer Hall. Enjoy great Supercraft beer, hard seltzers, wine, and a full bar menu alongside delicious including signature double smashed Burger, crispy chicken wings, giant pretzels, and more. 90 Washington St., clintonhallny.com
Fraunces Tavern- The historic locale, where Gen. George Washington bade farewell to his troops, features downhome comfort foods. 54 Pearl St., at Broad St., 212.968.1776, frauncestavern.com
Katz’s Delicatessen- This iconic spot has been serving pastrami, corned beef, knishes, pickles, and more since 1888 and has been featured in TV and films. 205 E. Houston St., at Ludlow St.,
212.254.2246, katzsdelicatessen.com
Tribeca Grill- The Robert De Niro/Drew Nieporent collaboration offers robust fare and an award-winning international wine list. 375 Greenwich St., at Franklin St., 212.941.3900, myriadrestaurantgroup. com
Veselka- This famous Eastern European spot serves up Ukrainian comfort foods, pierogis, breakfast specials and brunch classics. 144 2nd Ave.,212.228.9682, Veselka.com
Vestry- Few restaurants earn a Michelin star in the first year, but Vestry can boast that accomplishment with Chef Shaun Hergatt. A meal here is anything but ordinary. 246 Spring St., 212.784.1350, vestrynyc. com
Via Carota- The West Village gastroteca is old-world Tuscan in ambiance, food, and decor. Chefs Jody Williams and Rita Sodi were jointly named Best Chef in NYC at the 2019 James Beard Foundation Awards. L & D (daily). No reservations are accepted. 51 Grove St., btw 7th Ave. So. & Bleecker St., 212.255.1962, viacarota. com
Armani Ristorante- The famous style house has its own restaurant located inside its store on Fifth Avenue. 717 5h Ave. 212.207.1902, armani.com/restaurant
Black Tap Craft Burgers & Beer- Find a variety of over-the-top Insta-
grammable shakes and burgers at this colorful spot with comfort foods, burgers, salads and shakes. 136 W. 55th St., 212.315.4356, blacktap. com
Carnegie Diner and Cafe- Indulge in all-day breakfast, salads, burgers, and triple-decker sandwiches in addition to a variety of delicious desserts and drinks, including frozen margaritas. Indoor dining is also available, with 25 seats separated by screen protectors throughout the restaurant. 205 W. 57th St., 212.664.1001, carnegiediner.com
Estiatorio Milos- Upscale, authentic Greek cuisine and quality seafood options are staples of this foodie favorite with a popular set lunch menu special. 125 W. 55th St., 212.245.7400, estiatoriomilos.com
Gallow Green- A stunning garden-inspired indoor/outdoor space with seasonal cuisine and deliciously stylish craft cocktails. 542 W. 27th St., 212.904.1880, mckittrickhotel.com/gallow-green
Joe Allen- Pre and post-theater dining is a tradition at this warm go-to, known for its comfort food and posters of Broadway flops. 326 W. 46th St., btw 8th Ave. & 9th Ave., 212.581.6464, joeallenrestaurant.com
Keens Steakhouse- This historic restaurant is home to fantastic chops and the world’s largest collection of churchwarden pipes that date back to the early 20th century. 2 W. 36th St., 212.947.3636, keens. com
La Grande Boucherie- This charming spot serves up French cuisine in a stunning atrium-style space with a variety of classic dishes and twists on traditional favorites. 145 W. 53rd St., 212.510.7714, boucherie. nyc
Mermaid Oyster Bar- A seafood lover’s paradise filled with plentiful delicious raw and cooked options and even multiple choices for meat lovers. 127 W. 43rd St., 332.208.7713, themermaidnyc.com
Nerai- Experience refined and sophisticated Greek cuisine in the restaurant’s new outdoor garden. Nerai also has one of the most beautiful indoor settings in town, courtesy of a massive Jasmine garden. 55 E. 54th St., 212.759.5554, nerainyc.com
Patsy’s Italian Restaurant- This long-running, family-operated restaurantdating back to 1944, a favorite of the late Frank Sinatra, specializes in Neapolitan cuisine, including penne alla vodka and gnocchi with meat sauce. 236 W. 56th St., btw Broadway & 8th Ave., 212.247.3491, patsys.com
Petrossian Boutique and Cafe- This charming eatery just south of Central Park serves up caviar and smoked fish along with various pastries and a breakfast that is served all day. 911 7th Ave. at W. 58th St., 212.245.2217, petrossian.com
Philippe Chow- Upscale Chinese cuisine and exotic cocktails can be found in this sophisticated restaurant with classic Chinese
offerings. 33 E. 60th St., 212.644.8885, philippechow.com
Playa Betty’s- Take a tropical getaway at this brightly colored restaurant with a beachy setting and fun cocktails. 320 Amsterdam Ave., 212.712.0777, playabettys. com
Sable’s Smoked FishThis compact deli offers smoked fish, numerous meats by the pound, delicious deli sandwiches, and various prepared foods. 11330 3rd Ave. at E. 76th St., 212.249.6177, sablesnyc.com
Sarabeth’s- The quintessential brunch spot is also open for breakfast, lunch and dinner, so you can enjoy the delightful menu all day long. 40 Central Park S., 212.826.5959, sarabethsrestaurants.com
Serafina- Upscale Italian cuisine in a sophisticated, modern space with classic dishes. 210 W. 55th St., 212.315.1700, serafinarestaurant.com
Sugar Factory- A dessert lover’s dream, Sugar Factory serves colorful food, outrageous drinks, and desserts adorned with candy and other sweet confections and delightful gift items. 1991 Broadway, btw W. 67th St. & 68th St., 212.769.9500, sugarfactory.com
Tao- Famous for its giant Buddha and clublike atmosphere, Tao combines
exotic ambiance with upscale Asian specialties, including dim sum, small plates, and sushi. 42 E. 58th St., 212.888.2288, taorestaurant.com
The Mary Lane- The Mary Lane offers culinary delights within bright spaces filled with light. 99 Bank St., 212.597.9099, themarylanenyc.com
Zuma- A meal at Zuma is a true culinary treat. If you find the menu a little overwhelming, opt for the omakase experience. 261 Madison Ave., 212.544.9862, zumarestaurant.com
Amy Ruth’s- Enjoy traditional soul food cuisine and classic dishes at this popular Halem hotspot that locals and tourists both love. 113 W. 116th St., 212.280.8779 amyruths.com
Barawine Harlem- Dine on delicious French fare with an exquisite wine list and a fantastic bar menu to complement your drink. 200 Malcolm X Blvd., 646.756.4154, barawine.com
Cafe Luxembourg- This glamorous Art Deco Upper West Side bistro serves all the classics: cassoulet, steak tartare, coq au vin, steak frites, moules frites, and more. 200 W. 70th St., btw Amsterdam Ave. & West End Ave., 212.873.7411, cafeluxembourg.com
Clay—In the heart of Harlem, where a storied jazz club once stood, each meal at Clay is a celebration of bountiful harvests, beloved community, and our favorite pairing of food and friends. 553 Manhattan Ave., 212.729.1850, claynyc.com
Dagon- Located on the Upper West Side, Dagon serves up traditional Mediterranean favorites and various modern flavors. 454 Broadway, 212.873.2466, dagonnyc. com
The Grange- Microbrews, craft cocktails & area-sourced comfort fare are served in a roomy, rustic-chic space.1635 Amsterdam Ave., 212.491.1635, thegrangebarnyc.com
Gray’s Papaya- Famous for its delicious hot dogs, Gray’s Papaya has been featured on television and in numerous films for years. 2090 Broadway, 212.799.0243, grayspapaya.nyc
The Honeywell- Craft cocktails and bar bites are offered in a lowlit, subterranean setting with a cozy vibe. 3604 Broadway, 646.861.0489, thehoneywellnyc.com
Lolo’s Seafood ShackLoLo’s Seafood Shack serves up various seafood items like sauced shrimp to Caribbean street eats like crunchy conch fritters and seafood steampots. 303 W. 116th St., 646.649.3356,
lolosseafoodshack.com
Lexington Candy ShopThis old-school luncheonette is best known for its traditional diner menu, including all-day breakfast. 226 Lexington Ave., at E. 83rd St., 212.288.0057, lexingtoncandyshop.net
Max Brenner- Chocolate gifts, sweet treats and unique eats. 720 7th Ave., 646.467.8813, maxbrenner.com
Melba’s- Southern classics served in a retro setting that’s relaxed and homey by day, bustling in the evening. 300 W. 114th St, 212.864.7777, melbasrestaurant.com
The Mermaid Inn- Famous for its lobster rolls, The Mermaid Inn serves up seafood specials. 570 Amsterdam Ave., 212.799.7400, Themermaidnyc.com
ROKC- Microbrews, craft Japanese option for several varieties of ramen, plus snacks, a raw bar and sophisticated cocktails. 3452 Broadway, 332.217.8755, rokcnyc.com
Vinateria- Chic, contemporary spot pairing wine and cocktails with upscale Italian- & Spanish-influenced cooking. 2211 Frederick Douglass Blvd., 212.662.8462, vinaterianyc.com
For more listings and up-to-date information visit GoVisit.Guide
SONA offers a modern twist on traditional Indian dishes, with options ranging from tandoori meats to vegetarian curries. Enjoy shareable items like the Tikka Flatbread and Thali platters with choices like the Coastal Shrimp Curry and Paneer Lababdar. The restaurant also features an extensive cocktail menu, including unique options such as mango lassi-inspired drinks and spice-infused gin and tonics, with flavorful choices like the Hazel Lost in Manhattan, which features cardamom.
36 E. 20th St., 212.203.6460, sona-nyc.com
Try upscale contemporary Indian cuisine at Aroqa. The sleek space and traditional Indian classics provide the perfect combination. Diners can enjoy exclusive lunch specials, weekend brunch items (like the “Indian Masala Omelette”), and dinner items like the “Peri Peri Prawns” and “Shredded Crab With Lentil Soup Shots.” The menu features plenty of meat and seafood along with various vegan, vegetarian and gluten-free items. Aroqa also has numerous shareable plates like the “Goan Shrimp Curry” and the “Chef’s Special Goat Keema Matar.”
206 9th Ave., 646.678.5471, aroqanyc.com
Jaz offers a modern twist on traditional Indian cuisine, with dishes like tandoori shrimp and roasted eggplant with paneer. The restaurant also has a diverse cocktail and wine menu, making it a perfect spot for a special meal or evening out. The restaurant features a tasty set menu in addition to the a la carte options, where diners can try out items like the Lasuni Gobi and the Chicken Shahi Korma. If you’re catching a show, check out the Jaz pre-theatre menu with selections like the Onion Bhajia, Lamb Chettinad and Rasmalai.
813 9th Ave., 917.675.7440, jazindiancuisine.com
Honest is known for serving traditional vegetarian Indian street food, using its own proprietary spice blends and fresh ingredients cooked to order. Their signature dishes include Bhaji Pav and Pulav, and you’ll also find a selection of exotically-flavored sandwiches on the menu. The restaurant originally started as a small street cart in Law Garden, Ahmedabad, India, in the 1960s and has now expanded to a location in NYC’s Bleecker Street. They also have a bakery in New Jersey where they make fresh dinner rolls, or pav, for their Bhaji Pav dish.
176 Bleecker St., 917.261.2610, nychonest.com
Malai Marke in the Upper East Side brings great food and a great atmosphere to the table. In addition to its fusion dishes (like the Vegetable Hakka Noodles) and the imaginative takes on classic dishes (like the Chicken Tikka Kebab Rolls), the restaurant also offers traditional favorites like Butter Chicken and Vegetable Samosas. The atmosphere is casual and inviting, with warm decor and friendly staff. Overall, Malai Marke offers a unique dining experience with delicious and diverse Indian cuisine.
318 E. 6th St., 212.777.7729, malaimarke.com








Aire Ancient Bath- Let the soothing waters calm your body and mind. 88 Franklin St., 917.563.4542, beaire.com
Great Jones Spa- Enjoy upscale relaxation in restful spaces like the Chakra-Light Steam Room. 29 Great Jones St., 212.505.3185, gjspa. com
Heyday- Find locations throughout NYC. 1 W. 1 9th St., 212.796.7791; 382 Lafayette St., 212.796.7797; 1130 Broadway, 646.869.3601; 92 Reade St., 646.922.7576; 1459 3rd Ave., 212.796.7795; 67 W. 71st St., 212.796.7796; heydayskincare.com
Joanna Vargas- Cleanse your skin at this day spa using only clean ingredients. 501 5th Ave., 3rd Floor, Ste. 300,
212.949.2350, joannavargas.com
Coliseum Dental- Dont let a dental emergency ruin your visit to the Big Apple. 244 W. 54th St., Ste. 614; 251 E. 33rd St., 212.757.3183, coliseumdental.com
QC NY Spa- Luxurious European wellness experiences on Governor’s Island. Governors Island, 112 Andes Rd., 646.402.9647, qcny.com
Bergdorf Goodman- The emporium’s separate men’s and women’s stores offer designer labels and name brands, accessories and cosmetics. 754 5th Ave., btw 57th St. & 58th St., 212.753.7300, bergdorfgoodman.com
Bloomingdale’s- Browse
Saksfifthavenue.com
Pandora- The famous international jewelry chain store’s Times Square Location can be found right next to Bryant Park. Stop by for the perfect jewelry gifts and souvenirs. 110 W. 42nd St., 212.273.3267, stores.pandora.net
David Webb- Webb’s uniquely stunning gems have been worn by society doyennes and even Hollywood royalty. 942 Madison Ave., btw. E. 74th St. & E. 75th St., 212.421.3030, davidwebb. com
the most indemand styles for women, men, kids and homes in this famous shopping destination. 1000 3rd Ave., at E. 59th St., 212.705.2000, Bloomingdales.com
Macy’s Herald SquareThe iconic department store spans an entire city block. 151 W. 34th St., btw Broadway & 7th Ave., 212.695.4400, macys.com
Nordstrom- The seven-floor women’s flagship store offers clothing, accessories, shoes, beauty and dining options all under one roof. 225 W. 57th St. & Broadway, nordstrom. com
Saks Fifth Avenue- The women’s shoe salon occupies an entire floor of the luxury store for men and women. 611 5th Ave., btw 49th St. & 50th St., 212.753.4000,
Tiffany & Co.- Iconic jeweler selling diamonds, pearls, gold, silver, sterling flatware, fine timepieces, crystal and much more—all wrapped in the Tiffany & Co. signature robin’s egg blue boxes. 727 5th Ave., at 57th St., 212.755.8000, tiffany.com
Brookfield Place- Highend apparel and accessories brands for men, women and kids. You’ll also find numerous boutiques, bookstores, beauty shops and dining options. 230 Vesey St., btw West St. & Liberty St., 212.978.1698, brookfieldplaceny.com
Empire Outlets- The only outlet shopping center in New York City houses more than 100 designer outlet retailers, including H&M, Levi’s, Nike Factory, Gap and more. Easy access to and from Manhattan via the Island Ferry, less than a five-minute walk from the St. George Terminal. 55 Richmond Terrace.,
Staten Island, empireout lets.nyc
The Shops and Restau rants at Hudson YardsLuxury and specialty stores fill this multi-floor retail and dining destina tion. Find exotic cuisines and special gift and sou venir options here, along with unique experiences. 20 Hudson Yards, at 10th Ave. & W. 33rd St., hud sonyardsnewyork.com
The Shops at Columbus Circle- This shopping destination consists of more than 60 stores and dining options. The shopping center has numerous bars, a Central Park view, and more. 10 Columbus Cir., 212.284.9982, theshopsat columbuscircle.com

Westfield World Trade Center- Top-tier stores and designer shops include Apple, Roberto Coin, Longines and Stuart Weitzman. 185 Greenwich St., btw Vesey St. & Barclay St., 212.284.9982, westfield.com/westfieldworldtradecenter
American Girl Place- In addition to the popular historical and contemporary doll collection, the store sells doll accessories and matching doll and girl clothing. Café, hair salon and personal shopping are available too. 75 Rockefeller Plz., 877.247.5223, americangirl.com.
Disney Store- The Disney Store offers the latest in official Disney merchandise, including Disney toys, clothes and Disney collectibles featuring everyone’s favorite characters, including Mickey Mouse, Disney princesses and more. Times
Square, 1540 Broadway, 212.626.2910, Stores. shopdisney.com
FAO Schwarz- Shop at the biggest toy store in New York City! The world-famous FAO Schwarz is an experience truly unlike any other toy store. 30 Rockefeller Plaza, 800. 326-8638, faoschwarz.com
Kidding AroundLong-standing toy boutique stocked with all sorts of fun games, puzzles, dressup clothes & educational playthings for children of all ages. 60 W. 15th St., #1, 212.645.6337, kiddingaroundtoys.com
The Lego Store- The iconic toy retailer showcases the brand’s colorful building sets and bricks, plus figurines and toys from pop culture franchises like Harry Potter and Star Wars. 620
5th Ave., 212. 245.5973, lego.com
Nintendo NY- A 10,000 square foot store filled with interactive game demos, accessories, apparel and collectibles. Located in historic Rockefeller Center, Nintendo NY is your very own Warp Pipe into the Mushroom Kingdom and beyond! 10 Rockefeller Plaza, 646.459.0800, nintendonyc.com
Coach- The fashionable American leather goods brand is known internationally for its signature accessories and classic handbags. 143 Prince St., 212.473.6925, coach.com
Il Bisonte- Find highquality, well-designed handbags, briefcases and other accessories at
this Italian leather goods retailer’s flagship store. 381 Bleecker St., at Perry St., 212.633.0334, ilbisonte.com
Love Adorned- An open, airy space stocked with an eclectic mix of contemporary & vintage jewelry in addition to unusual home goods. 269 Elizabeth St., 212.431.5683, loveadorned.com
Miansai Soho- Narrow flagship vending stylish, handmade accessories for men like hook & rope bracelets. 33 Crosby St., 212.858.9710, miansai.com
Nike NYC- The athletic retailer’s New York store is one of only three stores in the world with the House of Innovation. 650 5th Ave., 212.376.9480, nike.com/ retail/s/nike-nyc-houseof-innovation


American Museum Of Natural History- Exhibition halls filled with dinosaur skeletons, fossils, dioramas, and more. The Hayden Planetarium is here, too. Central Park West, at W. 79th St., 212.769.5100, amnh.org
Broadway Museum- Experience the birth, history, and culture of Broadway through interactive exhibits and displays. 145 W. 45th St., themuseumofbroadway.com
Ellis Island National Museum of Immigration- Learn all about the immigration process and the journey new immigrants took to enter the United States. Ellis Island Bridge, Jersey City, NJ, 832.960.0009, libertyellisfoundation.org/immigration-museum
The Frick Collection- Old Master paintings, furnishings, and decorative arts in an early-20th-century limestone mansion. Ages ten and over only.1 E. 70th St., at Fifth Ave., 212.288.0700, frick.org
Fotografiska- Fotografiska aims to inspire a more conscious world through the power of photography. Founded in Stockholm in 2010, now Fotografiska has opened its newest outpost in a treasured, six-floor historic landmark building in NYC’s Flatiron District. 281 Park Ave. S., 212.433.3686, fotografiska.com/nyc
Guggenheim Museum- Frank Lloyd Wright’s landmark structure houses works of modern and contemporary art. 1071 Fifth Ave., at 89th St., 212.423.3500, guggenheim.org
Hip Hop Hall of Fame + MuseumLearn and experience the history of hip hop culture and music at this educational institute and museum.
New York City certainly has no shortage of museums. Whether you’re in the mood for art, history, culture or even the origins of ice cream, there’s a museum in the Big Apple that’s perfect for you.
131 W. 35th St., 8th Floor, Ste. M307, 347.709.2185, hiphophof.tv
Intrepid Sea, Air & Space Museum- An educational and cultural non-profit institution aboard an aircraft carrier. The space operates as a museum centered on the aircraft carrier Intrepid, space shuttle Enterprise, jets, and a guided missile submarine. Pier 86, W. 46th St., 212245-0072, intrepidmuseum.org
Jewish Museum- A wide range of stunning exhibits share Jewish culture and art with the world. 1109 Fifth Ave., 212.423.3200, thejewishmuseum.org
The Metropolitan Museum Of Art- American, European, and Far Eastern fine and decorative art and fashion fill this world-renowned encyclopedic museum. 1000 Fifth Ave., at 82nd St., 212.535.7710, metmuseum.org
The Morgan Library & Museum-
The private library of financier J. Pierpont Morgan is now a research facility and museum featuring rare books, manuscripts, drawings, and prints. 225 Madison Ave., at E. 36th St., 212.685.0008, themorgan.org
Museum of Chinese in AmericaThis museum gives an in-depth look into the lives of Chinese- Americans and the role that they played in American culture. 215 Centre St., 212.619.4785, mocanyc.org
Museum of Comic and Cartoon ArtPart of the Society of Illustrators, the Museum of Comic and Cartoon Art displays comics and cartoons throughout the ages and also houses workshops and an annual festival. 128 E. 63rd St., 212.838.2560,
societyillustrators.org
Museum of Ice Cream- I scream, you screa, we all scream for the Museum of Ice Cream. Explore exhibits full of the delightful sweet treat and enjoy various samples along the way. 558 Broadway, museumoficecream.com
Museum of Illusions- An Instagrammable assortment of illusions and exhibits. 77 8th Ave., 212.645.3230, newyork.museumofillusions.us
Museum of Modern Art- One of the world’s greatest repositories of late19th-, 20th- and 21st-century works of art. 11 W. 53rd St., btw Fifth Ave. & Sixth Ave., 212.708.9400, moma. org
Museum of Sex- Take a journey through the evolution of human sexuality. 233 5th Ave., 212.689.6337, museumofsex.com
National September 11 Memorial & Museum- A place for reflection and remembrance. Memorial: Open daily Free. Museum entrance: 180 Greenwich St., btw Liberty St. & Fulton St., 212.266.5211, 911memorial.org
Tenement Museum- The Museum’s two historical tenement buildings were home to an estimated 15,000 people, from over 20 nations, between 1863 and 2011. 103 Orchard St., 877.975.3786, tenement.org
Whitney Museum Of American ArtThis beautiful art museum houses a selection of 20th-century and contemporary American art and artists. 99 Gansevoort St., btw Washington St. & West St., 212.570.3600, whitney.org
New York City Map





